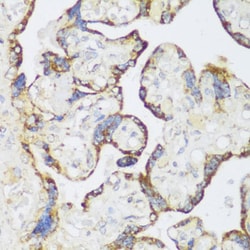
Invitrogen ECH1 Polyclonal Antibody 100 &mu;L; Unconjugated:Antibodies,

Learn More
Invitrogen™ ECH1 Polyclonal Antibody


Rabbit Polyclonal Antibody
Brand: Invitrogen™ PA588881
Description
Immunogen sequence: MAAGIVASRR LRDLLTRRLT GSNYPGLSIS LRLTGSSAQE EASGVALGEA PDHSYESLRV TSAQKHVLHV QLNRPNKRNA MNKVFWREMV ECFNKISRDA DCRAVVISGA GKMFTAGIDL MDMASDILQP KGDDVARISW YLRDIITRYQ ETFNVIERCP KPVIAAVHGG CIGGGVDLVT ACDIRYCAQD AFFQVKEVDV GLAADVGTLQ RLPKVIGNQS LVNELAFTAR KMMADEALGS GLVSRVFPDK EVMLDAALAL AAEISSKSPV AVQSTKVNLL YSRDHSVAES LNYVASWNMS MLQTQDLVKS VQATTENKEL KTVTFSKL; Positive Samples: A375, BxPC3, Hep G2, Jurkat, MCF7, K-562, Mouse testis, Rat liver; Cellular Location: Mitochondrion, Peroxisome.
This gene encodes a member of the hydratase/isomerase superfamily. The gene product shows high sequence similarity to enoyl-coenzyme A (CoA) hydratases of several species, particularly within a conserved domain characteristic of these proteins. The encoded protein, which contains a C-terminal peroxisomal targeting sequence, localizes to the peroxisome. The rat ortholog, which localizes to the matrix of both the peroxisome and mitochondria, can isomerize 3-trans,5-cis-dienoyl-CoA to 2-trans,4-trans-dienoyl-CoA, indicating that it is a delta3,5-delta2,4-dienoyl-CoA isomerase. This enzyme functions in the auxiliary step of the fatty acid beta-oxidation pathway. Expression of the rat gene is induced by peroxisome proliferators.
Specifications
| ECH1 | |
| Polyclonal | |
| Unconjugated | |
| ECH1 | |
| AA617331; delta(3,5)-Delta(2,4)-dienoyl-CoA isomerase, mitochondrial; delta3,5-delta2,4-dienoyl-CoA isomerase; delta3,5-delta2,4-dienoyl-coenzyme A isomerase; dienoyl-CoA isomerase; ECH1; enoyl CoA hydratase 1, peroxisomal; enoyl coenzyme A hydratase 1, peroxisomal; enoyl hydratase-like protein peroxisomal; enoyl hydratase-like protein, peroxisomal; enoyl-CoA hydratase 1; enoyl-CoA hydratase 1, peroxisomal; HPXEL; Peroxisomal enoyl hydratase-like protein; peroxisomal enoyl-CoA hydratase 1; peroxisomal/mitochondrial dienoyl-CoA isomerase; Pxel | |
| Rabbit | |
| Affinity Chromatography | |
| RUO | |
| 1891, 51798, 64526 | |
| -20°C, Avoid Freeze/Thaw Cycles | |
| Liquid |
| ELISA, Immunohistochemistry (Paraffin), Western Blot | |
| 0.08 mg/mL | |
| PBS with 50% glycerol and 0.01% thimerosal; pH 7.3 | |
| O35459, Q13011, Q62651 | |
| ECH1 | |
| Recombinant fusion protein containing a sequence corresponding to amino acids 1-328 of human ECH1 (NP_0013892). | |
| 100 μL | |
| Primary | |
| Human, Mouse, Rat | |
| Antibody | |
| IgG |
Your input is important to us. Please complete this form to provide feedback related to the content on this product.